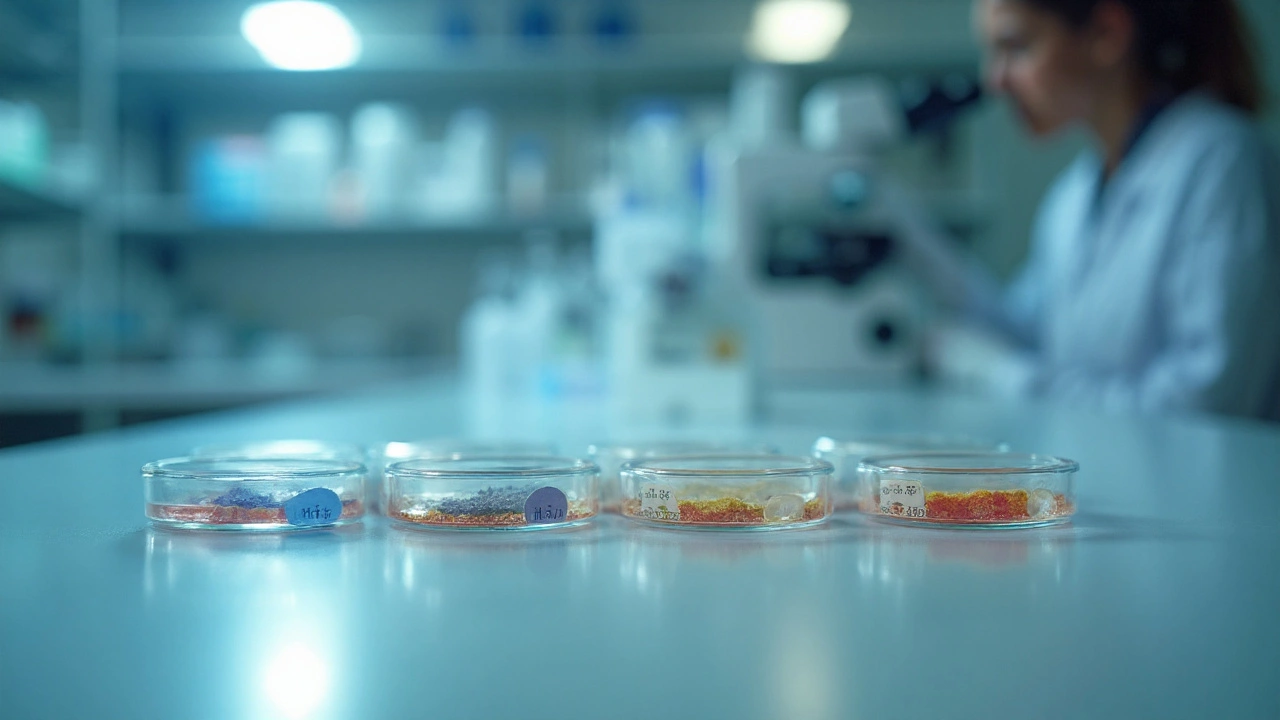

UTI Antibiotic Selector
Select your patient's characteristics to determine the best antibiotic choice for uncomplicated UTI treatment.
Nitrofurantoin is a nitrofuran‑derived antibiotic that concentrates in urine and kills common uropathogens such as Escherichia coli. It’s been a frontline option for uncomplicated urinary tract infections (UTIs) for decades, prized for low systemic toxicity and limited impact on gut flora.
How Nitrofurantoin Works
Once ingested, nitrofurantoin is rapidly reduced by bacterial flavoproteins to reactive intermediates that damage bacterial DNA, proteins and ribosomal function. This multi‑target attack makes it hard for microbes to develop resistance. The drug’s pharmacokinetic profile-rapid absorption, peak urine concentrations 30‑60minutes after a dose, and negligible plasma levels-means it acts where the infection lives while sparing the rest of the body.
When Nitrofurantoin Is the Right Choice
Guidelines from the Infectious Diseases Society of America (IDSA) list nitrofurantoin as a first‑line agent for acute uncomplicated cystitis in women, especially when E. coli resistance to other agents exceeds 20%.
- Typical dosing: 100mg twice daily for 5‑7days (adjusted to 50mg for patients with reduced creatinine clearance).
- Ideal for patients without severe renal impairment (eGFR≥30mL/min/1.73m²).
- Safe in most pregnancy trimesters, making it a go‑to for pregnant women with lower‑tract infections.
However, it’s not suitable for pyelonephritis, prostatitis, or in patients with a history of pulmonary toxicity.
Common Alternatives: What Else Is on the Shelf?
Three other oral agents dominate the outpatient UTI market:
- Trimethoprim‑sulfamethoxazole (TMP‑SMX) - a sulfonamide combo that inhibits bacterial folate synthesis.
- Fosfomycin - a phosphonic acid derivative given as a single 3g dose, entering the urinary tract unchanged.
- Fluoroquinolones (e.g., ciprofloxacin) - broad‑spectrum agents with excellent tissue penetration but rising resistance and safety concerns.
Each has a distinct mechanism, dosing schedule, safety profile, and place in therapy. Understanding those differences helps clinicians avoid unnecessary side effects and preserve antibiotic effectiveness.
Head‑to‑Head Comparison
| Attribute | Nitrofurantoin | TMP‑SMX | Fosfomycin | Fluoroquinolones |
|---|---|---|---|---|
| Mechanism | DNA‑damaging nitrofuran metabolites | Folate pathway inhibition | MurA enzyme inhibition (cell‑wall synthesis) | DNA gyrase/topoisomerase inhibition |
| Typical dose | 100mg BID 5‑7days | 800mg/160mg BID 3days | 3g single dose | 250‑500mg BID 3‑5days |
| Renal limit | eGFR≥30mL/min | eGFR≥15mL/min | eGFR≥10mL/min (adjusted) | No strict limit but dose‑adjust if eGFR<30 |
| Pregnancy safety | Category B (safe) | Category D (avoid first trimester) | Category B (safe) | Category C (use cautiously) |
| Key side effects | Pulmonary, hepatic, GI upset | Rash, Stevens‑Johnson, hyperkalemia | Diarrhea, transient taste change | Tendon rupture, QT prolongation |
| Resistance rates (U.S., 2023) | ~5% | ~15% | ~2% | ~12% |
The table shows why nitrofurantoin often beats the competition for uncomplicated cystitis: low resistance, pregnancy safety, and a short, well‑tolerated course. TMP‑SMX remains useful where local resistance is below 20% and patients have no sulfa allergy. Fosfomycin shines for patients who miss doses or need a one‑off solution. Fluoroquinolones are reserved for complicated cases or when other agents fail.
Safety, Side‑Effects & Special Populations
Pregnant patients deserve a dedicated look. Nitrofurantoin’s CategoryB rating means animal studies show no fetal risk, and human data are reassuring when used after 20weeks. TMP‑SMX carries a CategoryD label because of potential neural‑tube defect risk in the first trimester. Fosfomycin enjoys a CategoryB status, making it another safe alternative. Fluoroquinolones fall into CategoryC; clinicians avoid them unless the infection is severe.
Older adults often have reduced renal function. Because nitrofurantoin relies on urinary excretion, dosing must be adjusted or the drug avoided if eGFR drops below 30mL/min. TMP‑SMX tolerates lower eGFR but carries a higher risk of hyperkalemia in the elderly. Fosfomycin’s single‑dose regimen reduces monitoring burden, yet dose reduction is advised if eGFR<10mL/min.
Rare but serious toxicities deserve attention. Pulmonary toxicity can present as dry cough or dyspnea after weeks of therapy; clinicians should stop nitrofurantoin immediately if symptoms arise. Hepatotoxicity, though uncommon, manifests as jaundice and elevated transaminases. In contrast, fluoroquinolones can cause tendon rupture, especially in patients over 60 or on steroids.
Practical Decision Guide for Clinicians
- Assess pathogen susceptibility. If E. coli sensitivity shows <5% resistance to nitrofurantoin, choose it.
- Check renal function. eGFR≥30mL/min? Nitrofurantoin is okay. Below that? Consider TMP‑SMX (if eGFR≥15) or fosfomycin.
- Identify special populations. Pregnant? Stick with nitrofurantoin or fosfomycin. Allergy to sulfa? Avoid TMP‑SMX.
- Consider adherence. If the patient struggles with twice‑daily dosing, fosfomycin’s single‑dose might improve compliance.
- Review recent antibiotic exposure. Prior fluoroquinolone use raises the chance of resistant organisms; nitrofurantoin remains effective.
Applying this algorithm cuts unnecessary broad‑spectrum use and helps preserve antibiotic stewardship goals.
Related Concepts and Further Reading
Understanding nitrofurantoin’s place in therapy also means grasping broader topics like Antibiotic stewardship, regional UTI resistance patterns, and the role of urine culture in guiding treatment. Clinicians often move from the narrow focus on a single drug to these larger frameworks to ensure optimal patient outcomes.

Frequently Asked Questions
Can nitrofurantoin be used for kidney infections?
No. Nitrofurantoin concentrates only in urine and does not reach therapeutic levels in kidney tissue, so it’s ineffective for pyelonephritis.
What makes nitrofurantoin resistant strains so rare?
The drug creates multiple reactive metabolites that attack DNA, proteins, and ribosomes simultaneously. This multi‑target attack makes it hard for bacteria to develop a single resistance mechanism, keeping nationwide resistance below 5%.
Is nitrofurantoin safe for elderly patients with mild kidney decline?
It’s safe if the estimated glomerular filtration rate (eGFR) stays above 30mL/min/1.73m². Below that, the drug may not achieve adequate urine concentrations, and alternative agents should be considered.
How does fosfomycin compare in cost to nitrofurantoin?
In most Australian pharmacies, a single 3g fosfomycin tablet costs roughly AUD45, while a 5‑day course of nitrofurantoin (10×100mg tablets) is about AUD18. Fosfomycin’s higher price is offset by its one‑dose convenience.
When should a clinician switch from nitrofurantoin to another antibiotic?
Switch is advised if the patient develops pulmonary symptoms, significant liver enzyme elevation, or if a urine culture shows a pathogen resistant to nitrofurantoin. Also, if renal function falls below the therapeutic threshold during treatment, an alternative should be chosen.






Shaik Basha
September 25, 2025 AT 21:15Nitrofurantoin is king for UTIs, bro!
Michael Ieradi
September 28, 2025 AT 04:48Interesting breakdown; the data is solid, but remember, real‑world adherence matters.
Stephanie Zuidervliet
September 30, 2025 AT 12:21Wow!!! This article just exploded my mind!!! Nitrofurantoin sounds like the superhero of bladder infections, yet the tables feel so… dull!!!
Olivia Crowe
October 2, 2025 AT 19:55Great overview – very useful for anyone figuring out the right pick.
Aayush Shastri
October 5, 2025 AT 03:28In India we often rely on nitrofurantoin for uncomplicated cystitis because the resistance patterns are similar to what you described. Just make sure the eGFR is above 30, otherwise we shift to fosfomycin.
Quinn S.
October 7, 2025 AT 11:01While the article is informative, it contains several grammatical oversights. For instance, “It’s been a frontline option” should read “It has been a frontline option.” Moreover, consistency in pluralization is lacking.
Dilip Parmanand
October 9, 2025 AT 18:35Keep pushing the good guidelines – nitrofurantoin saves many from nasty side‑effects.
Sarah Seddon
October 12, 2025 AT 02:08Love how you broke down each drug! 🎉 Nitrofurantoin’s low impact on gut flora is a real lifesaver – especially for patients with sensitive stomachs.
Ari Kusumo Wibowo
October 14, 2025 AT 09:41Nice work, but let’s not forget that fluoroquinolones still have a place when resistance spikes – just use them wisely.
Ravikumar Padala
October 16, 2025 AT 17:15Alright, let me unpack this step by step. First, the pharmacokinetics of nitrofurantoin are indeed favorable for lower‑tract infections because the drug concentrates in the urine, reaching levels far above the MIC for common uropathogens. Second, the safety profile is generally good, but we must be vigilant about pulmonary toxicity – reports, although rare, highlight the need for patient monitoring, especially in those with prior lung disease. Third, the renal threshold of eGFR ≥30 mL/min is a hard cutoff; dosing adjustments below this level do not magically make the drug safe, so alternative agents should be considered. Fourth, during pregnancy, nitrofurantoin is acceptable in the second and third trimesters, yet it is contraindicated near term due to the risk of neonatal hemolysis, so clinicians must time therapy appropriately. Fifth, resistance development is slowed by the drug’s multi‑target mechanism, yet resistant strains have been documented in regions with overuse, which underscores the importance of stewardship. Sixth, when comparing to TMP‑SMX, the article correctly notes that nitrofurantoin shines when local E. coli resistance exceeds 20 %, but one must also remember that TMP‑SMX remains cheap and effective when susceptibility is confirmed. Seventh, fosfomycin’s single‑dose regimen is convenient, but the cost is higher and its spectrum is limited; it’s a solid fallback when nitrofurantoin cannot be used. Eighth, fluoroquinolones, while potent, carry black‑box warnings for tendon rupture, QT prolongation, and CNS effects – hence their reserved status. Ninth, the table’s layout could be improved; aligning doses under each drug would aid readability. Tenth, the article omitted discussion of side‑effects like GI upset, which are common with nitrofurantoin and may affect compliance. Eleventh, the disclaimer about not using nitrofurantoin for pyelonephritis is spot on – tissue penetration is insufficient. Twelfth, patient education about completing the full course is essential regardless of symptom resolution. Thirteenth, it would be helpful to include an algorithm for clinicians to follow based on renal function and pregnancy status. Fourteenth, the interactive calculator is a nice tool, but it should warn users about the limitations of using resistance percentages without local antibiograms. Fifteenth, overall, the piece is thorough and clinically useful, provided the reader keeps the caveats in mind. Finally, keep updating the content as resistance patterns evolve – antimicrobial stewardship is an ongoing battle.
King Shayne I
October 19, 2025 AT 00:48nice info but watch out for typos
jennifer jackson
October 21, 2025 AT 08:21Very helpful – thanks for sharing!
Brenda Martinez
October 23, 2025 AT 15:55Honestly, the article glosses over the severe adverse effects of nitrofurantoin. Pulmonary fibrosis isn’t a trivial footnote, and the narrative seems eager to push it as the default without weighing those risks adequately. Moreover, the piece hints at “low systemic toxicity” while ignoring the documented cases of hepatic injury. It feels more like marketing than balanced medicine.
Marlene Schanz
October 25, 2025 AT 23:28The comparison table is useful, but adding a column for common side‑effects would make it even more practical for clinicians.
Matthew Ulvik
October 28, 2025 AT 06:01Great job! This guide is super clear and will help a lot of us choose the right drug. :)
Dharmendra Singh
October 30, 2025 AT 13:35In many South Asian settings, nitrofurantoin remains a backbone drug, but we must always cross‑check local resistance data before prescribing.
Rocco Abel
November 1, 2025 AT 21:08Some might not realize that the push for nitrofurantoin is part of a larger agenda to marginalize older antibiotics that are cheaper for the pharma industry. Stay vigilant.
Dawn Mich
November 4, 2025 AT 04:41That's a baseless claim. There's no evidence that pharmaceutical lobbying dictates guideline recommendations for nitrofurantoin. Let's keep the focus on data.
Eric Sevigny
November 6, 2025 AT 12:15Overall solid overview. Just a reminder: always adjust dosing for patients with borderline renal function – even a slight drop can tip the balance.
Glenda Rosa
November 8, 2025 AT 19:48While nitrofurantoin looks shiny, remember that fosfomycin's single‑dose regimen actually beats it in patient compliance – a fact most mainstream sources conveniently ignore.